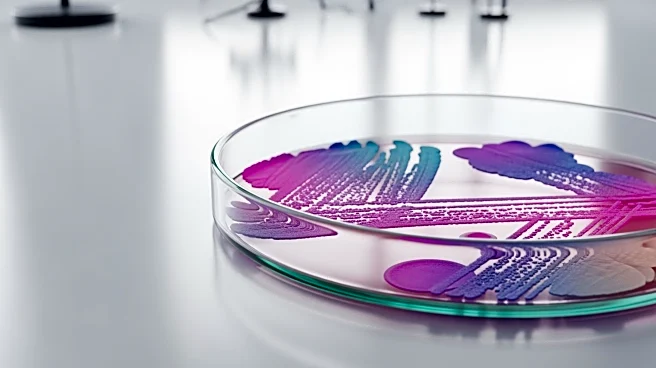
University of Cambridge Identifies Key Gut Bacteria Linked to Health

What is the story about?
What's Happening?
Las Vegas has experienced a decline in visitor numbers for the sixth consecutive month, with a 12% drop in July compared to the previous year. Despite this downturn, Steve Hill, CEO of the Las Vegas Convention and Visitors Authority (LVCVA), remains optimistic about the city's appeal across various price points. Hill emphasized that while monthly figures fluctuate, Las Vegas continues to offer competitive options for travelers. The city is actively addressing concerns about costs, with resorts implementing promotions such as waiving resort fees and offering free parking. Additionally, convention attendance showed a mixed trend, with a 10% decrease in June followed by a 10% increase in July. International travel to Las Vegas presents a varied picture, with a decline in Canadian visitors but an increase from Mexico, the UK, and Australia.
Why It's Important?
The decline in visitor numbers is significant for Las Vegas, a city heavily reliant on tourism and gaming revenue. Despite fewer visitors, Nevada's gaming revenue remains strong, indicating that those who do visit are spending more. This resilience in gaming revenue is crucial for the local economy, which benefits from the influx of tourists. The efforts by resorts to offer promotions and budget-friendly options are aimed at countering the narrative that Las Vegas is overpriced. The city's ability to attract international visitors, despite challenges such as visa fees and tariffs, is vital for maintaining its status as a global tourist destination. The mixed results in convention attendance also highlight the importance of business travel in sustaining Las Vegas's economy.
What's Next?
Looking ahead, Las Vegas is expected to see increased momentum in the fall, driven by a packed events calendar and stronger bookings into December. The city is focusing on promoting budget tips and free activities to attract more visitors. The LVCVA is optimistic about the next 16 months of bookings, which are projected to be strong. Additionally, addressing international travel barriers, such as visa fees and processing times, could further boost visitor numbers. The city's efforts to counter the perception of being overpriced will continue to play a crucial role in attracting tourists.
Beyond the Headlines
The decline in visitor numbers raises questions about the long-term sustainability of Las Vegas's tourism model, which has traditionally relied on high spending from visitors. The city's efforts to offer value and budget-friendly options may signal a shift towards a more inclusive approach to tourism. Additionally, the impact of international politics and tariffs on travel patterns highlights the interconnectedness of global events and local economies. Las Vegas's ability to adapt to these challenges will be crucial in maintaining its status as a premier tourist destination.